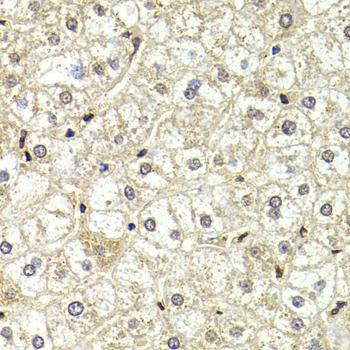
Anti-LMNB2 Antibody Anti-LMNB2 Antibody

Anti-LMNB2 Antibody
A39814
ApplicationsImmunoFluorescence, Western Blot
Product group Antibodies
ReactivityHuman
Overview
- SupplierAntibodies.com
- Product NameAnti-LMNB2 Antibody
- Delivery Days Customer7
- ApplicationsImmunoFluorescence, Western Blot
- CertificationResearch Use Only
- ClonalityPolyclonal
- Concentration1.0 mg/ml
- ConjugateUnconjugated
- HostRabbit
- Scientific DescriptionRabbit polyclonal antibody to LMNB2
- ReactivityHuman
- UNSPSC12352203

![Lane 1: Marker [kDa] 250, 130, 95, 72, 55, 36, 28, 17, 10. Lane 2: Human cell line RT-4. Lane 3: Human cell line U-251 MG. Lane 4: Human plasma. Lane 5: Human Liver tissue. Lane 6: Human Tonsil tissue](https://atlasantibodies.s3.amazonaws.com/images/wb/hpa047863-wb-1.jpg)


![Lamin B2 antibody [N3C2], Internal detects LMNB2 protein by western blot analysis. A. 30 μg Neuro2A whole cell lysate/extract B. 30 μg GL261 whole cell lysate/extract C. 30 μg C8D30 whole cell lysate/extract D. 30 μg NIH-3T3 whole cell lysate/extract E. 30 μg BCL-1 lysate/extract F. 30 μg Raw264.7 whole cell lysate/extract G. 30 μg C2C12 whole cell lysate/extract 7.5% SDS-PAGE Lamin B2 antibody [N3C2], Internal (GTX109894) dilution: 1:500 The HRP-conjugated anti-rabbit IgG antibody (GTX213110-01) was used to detect the primary antibody.](https://www.genetex.com/upload/website/prouct_img/normal/GTX109894/GTX109894_40079_WB_M_w_23060500_465.webp)

